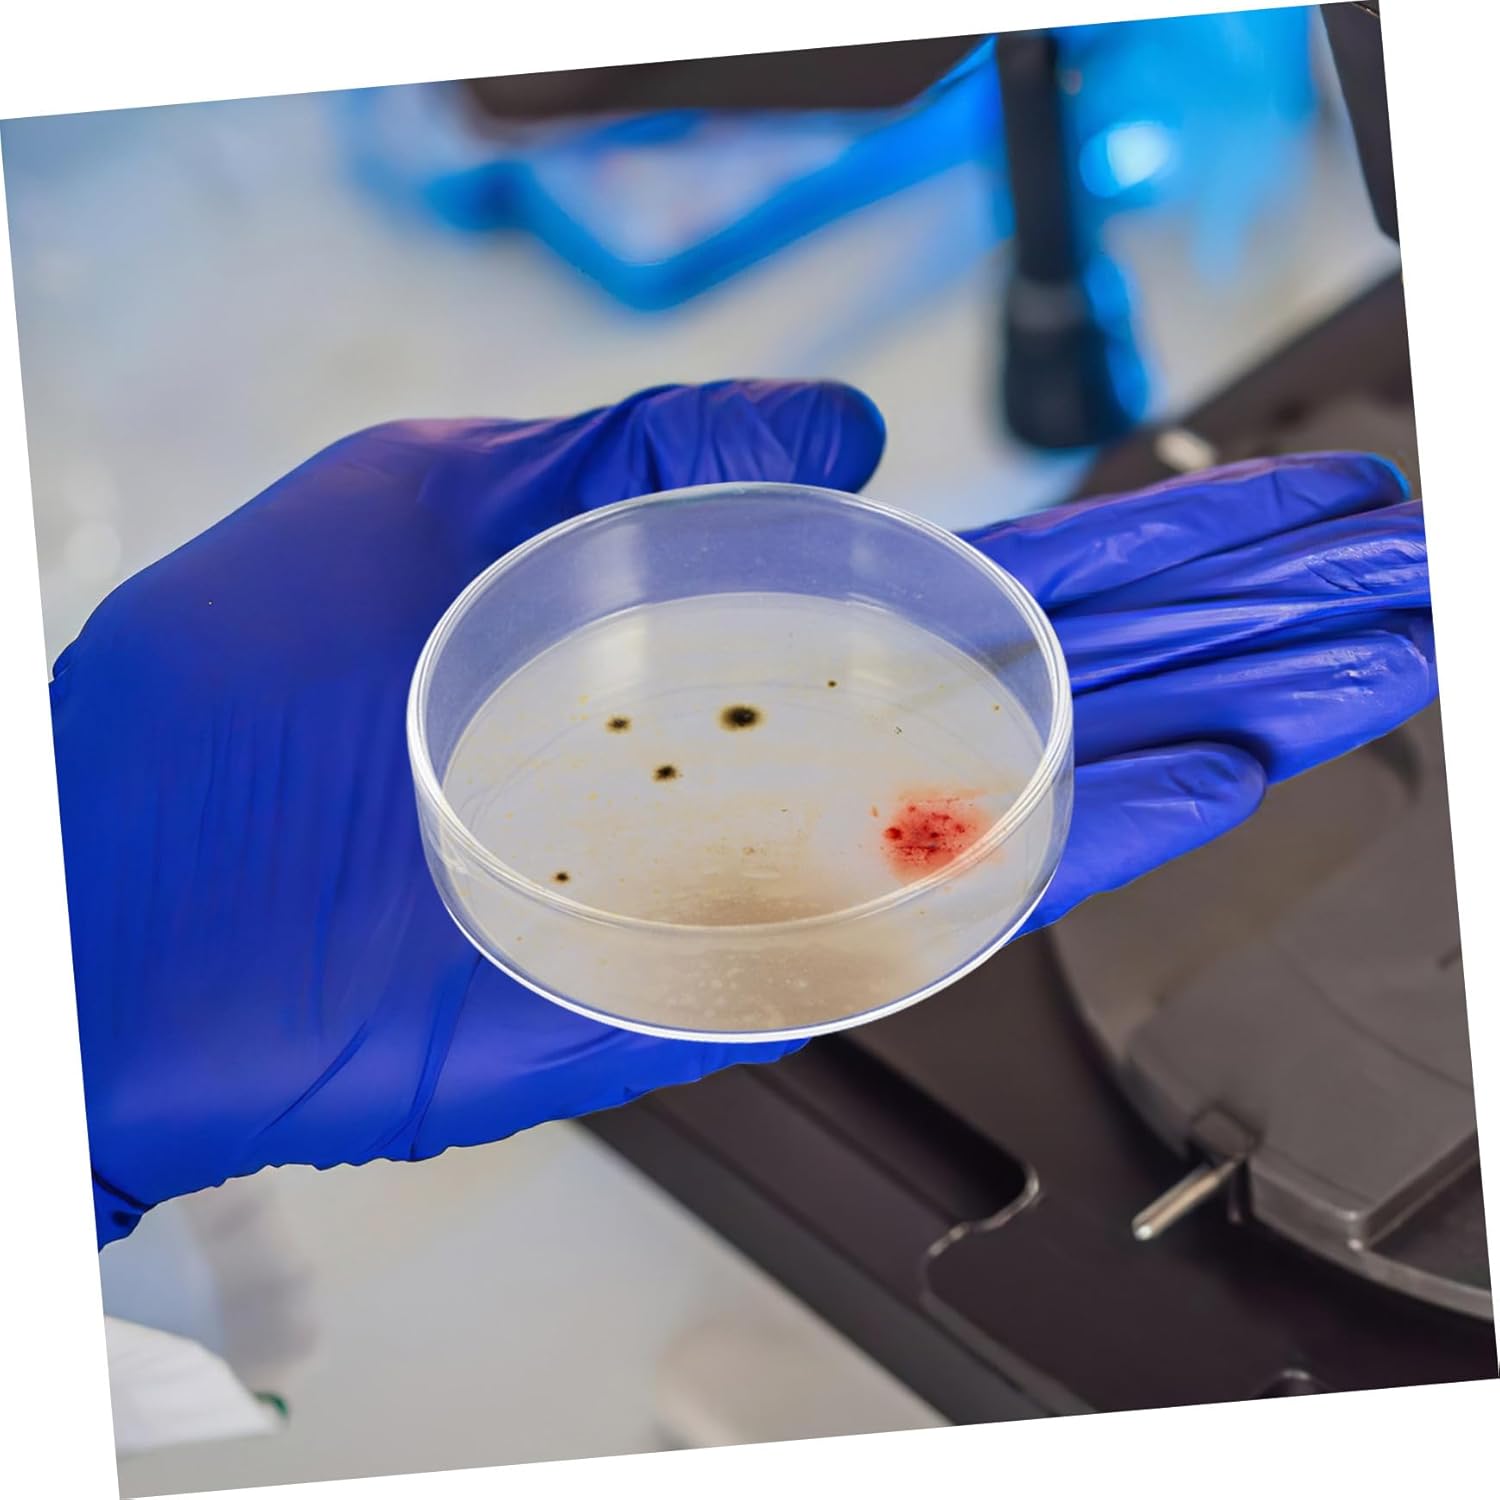

New
Arrivals/Restock
10pcs Glass Culture Dishes for Laboratory Experiments High Transparency Petri Dishes for Microscopic Observations for Science Kits and Educational Training
 Limited Time Sale
Limited Time SaleUntil the end
16
08
01
$19.91 cheaper than the new price!!
Free shipping for purchases over $99 ( Details )
Free cash-on-delivery fees for purchases over $99
Free cash-on-delivery fees for purchases over $99
See all stores
Please note that the sales price and tax displayed may differ between online and in-store. Also, the product may be out of stock in-store.
New $33.19
Product details
| Management number | 211013963 | Release Date | 2026/04/04 | List Price | $13.28 | Model Number | 211013963 | ||
|---|---|---|---|---|---|---|---|---|---|
| Category | |||||||||
- glass: made fromborosilicate glass, these culture dishes are reusable and resistant to temperatures, providing durability for various lab
- Enhanced visibility: the clear, bubblefree glass allows for easy and accurate observation of samples under a microscope, making it ideal for mycological studies
- Multipurpose: these dishes are great for laboratory training, children's science experiments, and even themed birthday parties, offering a wide range of educational uses
- Clear microscopy: the optical clarity of these plates ensures precise and detailed observations during microscopic examinations, crucial for accurate research
- Consistent cell growth: designed with a flat, smooth surface, these dishes promote uniform cell growth without clumping, and the vented lids ensure proper ventilation and protection
Correction of product information
If you notice any omissions or errors in the product information on this page, please use the correction request form below.
Correction Request Form